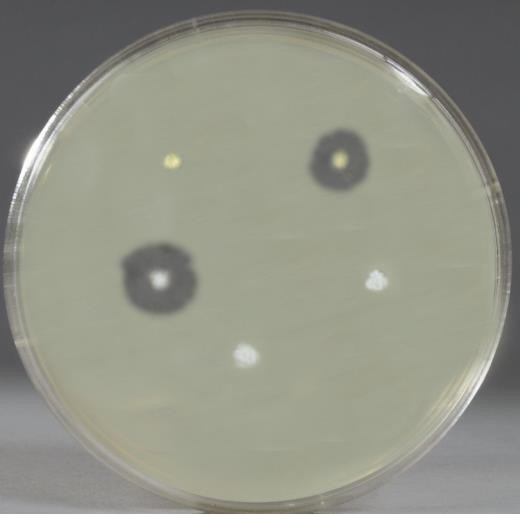
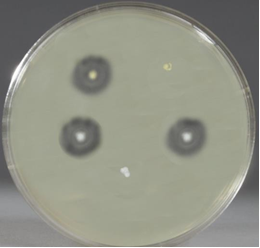
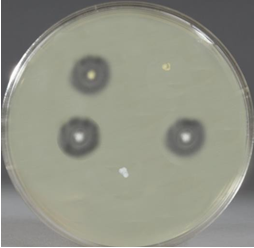
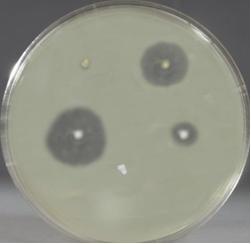
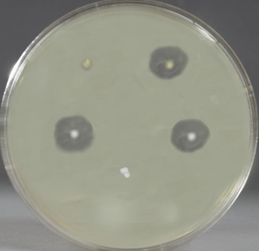
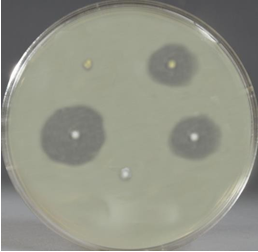
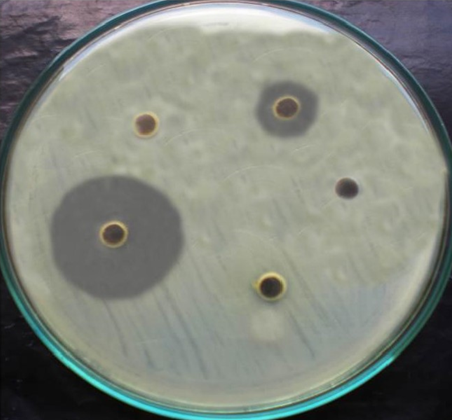
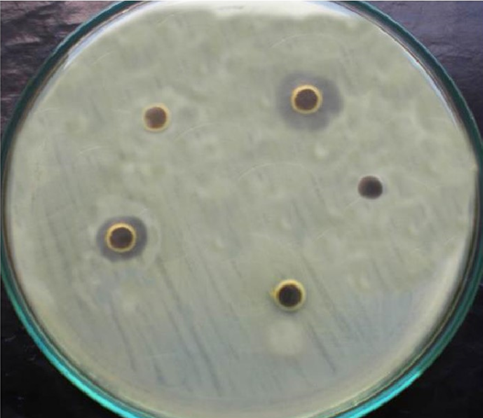
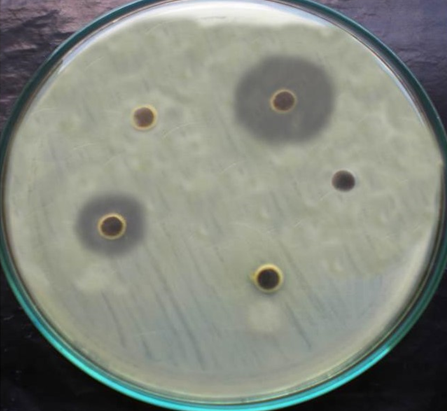
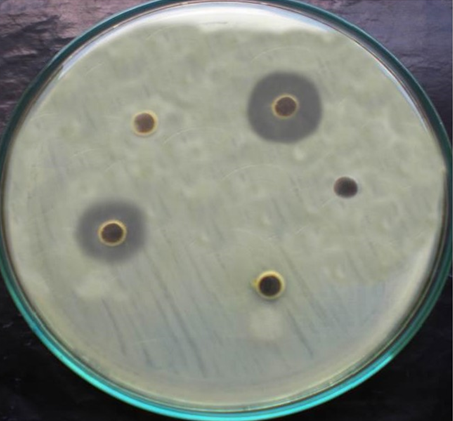
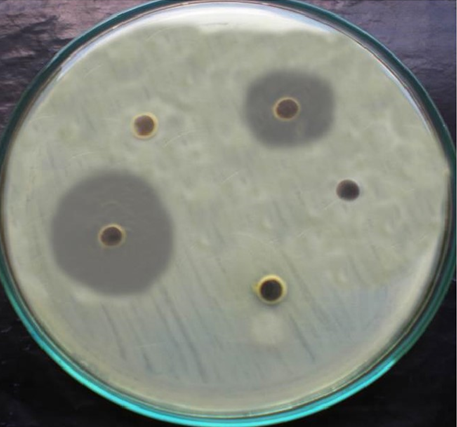
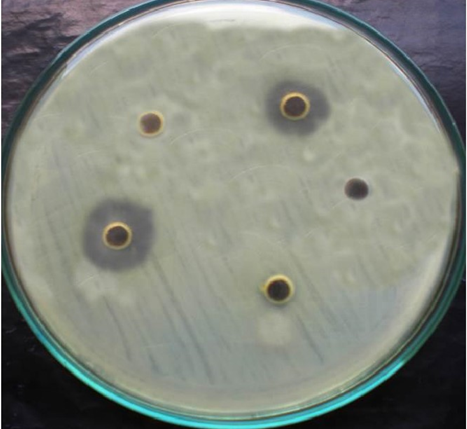

Int J Curr Pharm Res, Vol 14, Issue 3, 53-57Original Article
ISOLATION AND SCREENING OF MARINE BACTERIAL ISOLATES AGAINST CLINICAL PATHOGENS
D. SANGEETHA*, J. THARANI, R. ISHWARYA, P. RAMYA
Department of Microbiology, Faculty of Science, Annamalai University, Annamalai Nagar 608002, Tamil Nadu, India
Email: sangeethadau@gmail.com
Received: 25 Jan 2022, Revised and Accepted: 22 Mar 2022
ABSTRACT
Objective: The marine organism produce a large array of metabolites with relevants in drug discovery, these metabolites have biological activity such as antibacterial, antioxidant and antitumor. The present study was undertaken to isolate marine bacteria from the marine soil sample and were tested against clinical pathogens.
Methods: The soil sample were collected in a sterile plastic sachet. The isolates were enumerated using the spread plate technique in Zobell marine agar. The ten isolated marine bacteria were tested against six clinical pathogens by the point inoculation method and agar well diffusion method.
Results: Among ten bacterial isolates M5 exhibited a maximum antibacterial activity and it was identified as Pseudomonas japonica by 16S rRNA sequencing.
Conclusion: It can be concluded that isolation of Marine bacterial samples can offer a numbers of microbial strains for sources of new biomolecules from Marine sources.
Keywords: Marine bacteria, Secondary metabolites, Antibiotic proteins, Clinical pathogens
© 2022 The Authors. Published by Innovare Academic Sciences Pvt Ltd. This is an open-access article under the CC BY license (https://creativecommons.org/licenses/by/4.0/)
DOI: https://dx.doi.org/10.22159/ijcpr.2022v14i3.1987 Journal homepage: https://innovareacademics.in/journals/index.php/ijcpr
INTRODUCTION
Marine bacteria are normal biota of the marine environments and found in marine sediments, oceans, and other surfaces of marine living organisms [1-3]. Over the past decade, microorganisms have been recognized as an important and untapped resource for many unique novel bioactive compounds of clinical significance [4]. All organisms in nature compete with each other for their survival in their biological niches. This survival strategy is very well established in the case of microorganisms. Such survival mechanisms are achieved by the production of toxin, inhibitory enzymes and several antimicrobial agents inhibiting the other bacteria in their surrounding habitat. Such inhibitory compounds are generally secondary metabolites and are synthesized primarily for their survival against the other microorganisms [5, 6].
Many of the earlier reports on novel secondary metabolites were on isolation of low molecular weight antibiotic compounds from various marine bacteria [7]. Terrestrial bacteria synthesize several antibiotic proteins known as bacteriocins and many of them are well characterized. Similarly, marine bacteria are also an excellent source of various antibiotic proteins and polypeptides such as the nisin and subtilin [8, 9]. The overuse of antibiotics has caused an increase of multiple drug-resistant organisms mainly that belong to the genera Pseudomonas, Acinetobacter, Streptococcus and Staphylococcus [10, 11]. Microorganisms develop resistance to antibiotics because of mutations caused in their genome and by incorporating foreign genomic material like plasmids. To overcome these problems, in the present study, marine soil samples were analyzed for natural antibiotic-producing strains.
MATERIALS AND METHODS
Sample collection
Marine soil sample was collected from Pichavaram, Chidambaram, Cuddalore district. The soil samples were collected in a sterile plastic sachet and sealed aseptically and were stored in refrigeration until processing.
Enumeration of bacteria from marine soil sample
The spread plate technique was followed for isolating bacteria from the marine soil samples using ZM agar. The plates were incubated at 37 ᵒC for 24 h to obtain colonies. The individual colonies were picked upon the basis of their macroscopic characteristics such as size, shape, surface appearance, texture and color. The colonies were purified by repeated streaking and were sub-cultured onto Zobell Marine Agar slants. The marine bacterial isolates so obtained were stored at 4 ᵒC, for further study.
Screening of marine isolates for their antibacterial activity
Ten marine bacterial isolates were tested for their antibacterial activity against six clinical pathogens.
Point inoculation method
The overnight grown cultures of the clinical pathogens in Zobell Marine Broth were used to swab uniformly on the surface of the ZMA plates using sterile cotton swabs. The marine isolates from the agar slants were spotted onto Zobell Marine Agar plates seeded with actively growing cells of clinical pathogens. The plates were incubated for 24 h at 37 °C. After the incubation period, the plates were observed for zone of inhibition and the results were recorded.
Agar-well diffusion method
The antimicrobial activity of marine isolates was tested by the agar-well diffusion method. The overnight cultures of the clinical pathogens in Zobell Marine Broth were uniformly swabbed on the surface of the Zobell Marine Agar plates using sterile cotton swabs. Four wells of 6 mm size were made with sterile cork borer on the seeded plates. Around 100μl of overnight grown cultures from ZM Broth, was added to each well aseptically incubated 24 h at 37 °C and the inhibition zone was observed and recorded. The marine strains showing promising activities against clinical pathogens were selected for further identification.
Identification of marine bacterial isolate
Morphological characterization
The bacterial identification was done according to the scheme for Gram-positive bacteria [10] and the Gram-negative bacteria [11].
Table 1: 16S rRNA sequencing of the isolate
| Primer details primer name | Sequence details | Number of base |
| 8F | 5'AGAGTTTGATCCTGGCTCAG3' | 20 |
| 1541R | 5'AAGGAGGTGATCCAGCCGCA3' | 20 |
RESULTS
Isolation and identification of Bacteria
Ten bacterial colonies were isolated based on their morphological and structural characteristics (table 2).
Screening of marine isolates for their antibacterial activity
Screening of antimicrobial activity of ten isolates was carried out against seven clinical pathogens. In the point inoculation method, marine isolates from agar-slants were spotted on to the Zobell Marine Agar. Inhibitory activity against at least one clinical pathogen was detected for all the marine isolates (table 3). Among the seven clinical pathogens tested against isolated strains, the M5 isolate exhibited a maximum zone of inhibition against all the tested organisms followed by M6 and M2.
After screening by the point-inoculation method, the antibacterial activity was confirmed by the agar well diffusion method. Inhibitory activity against at least one Clinical pathogen was detected for six marine isolates (table 4).
Table 2: Morphological characteristics of marine isolates
| Marine isolates | Shape | Margin | Elevation | Size | Texture | Appearance | Pigmentation | Optical property |
| M1 | Circular | Entire | Raised | Small | Smooth | Shiny | Pigmented (orange) | Opaque |
| M2 | Circular | Curled | Flat | Large | Rough | Dull | Nonpigmented (cream) | Opaque |
| M3 | Circular | Entire | Flat | Pinpoint | Smooth | Shiny | Pigmented (yellow) | Opaque |
| M4 | Circular | Entire | Raised | Small | Rough | Dull | Nonpigmented (cream) | Opaque |
| M5 | Circular | Curled | Flat | Moderate | Rough | Dull | Nonpigmented (cream) | Opaque |
| M6 | Circular | Entire | Raised | Small | Smooth | Shiny | Nonpigmented | Transparent |
| M7 | Irregular | Curled | Raised | Moderate | Smooth | Shiny | Nonpigmented (cream) | Opaque |
| M8 | Circular | Entire | Raised | Small | Smooth | Shiny | Nonpigmented | Transparent |
| M9 | Circular | Entire | Raised | Small | Smooth | Shiny | Nonpigmented | Transparent |
| M10 | Circular | Entire | Flat | Pinpoint | Rough | Dull | Pigmented (yellow) | Opaque |
Table 3: Antibacterial activity of the marine isolates by point inoculation method
| Clinical pathogens | Zone of inhibition (MM) | |||||||||
| M1 | M2 | M3 | M4 | M5 | M6 | M7 | M8 | M9 | M10 | |
| Bacillus subtilis | _ | 7 | _ | _ | 8 | 8 | _ | _ | _ | _ |
| Bacillus cereus | _ | 5 | _ | 6 | 5 | 8 | _ | 9 | _ | _ |
| Staphylococcus aureus | _ | 15 | 5 | _ | 18 | _ | _ | _ | _ | _ |
| S. epidermidis | _ | 12 | 11 | _ | 20 | 6 | _ | _ | _ | _ |
| Strep. pyogenes | ||||||||||
A |
B |
C |
D |
E |
F |
Fig. 1: Antibacterial activity of the marine isolates by point inoculation method
Table 4: Antibacterial activity of the marine isolates by agar-well diffusion method
| Clinical pathogens | Zone of inhibition (MM) | |||||||||
| M1 | M2 | M3 | M4 | M5 | M6 | M7 | M8 | M9 | M10 | |
| Bacillus subtilis | _ | 9 | _ | _ | 29 | 11 | _ | _ | _ | _ |
| Bacillus cereus | _ | 9 | _ | _ | 6 | 14 | _ | _ | _ | _ |
| Staphylococcus aureus | _ | 11 | _ | _ | 9 | _ | _ | _ | _ | _ |
| Escherichia coli | _ | 9 | _ | _ | 13 | _ | _ | _ | _ | _ |
The antibacterial activity of marine isolates was studied by Agar Well Diffusion Assay method. Four marine isolates inhibited the growth of Klebsiellapneumoniae. The isolate M5 presented the highest inhibition zone (29 mm) against Bacillus subtilis. Three marine isolates inhibited the growth of Bacillus subtilis, Bacillus cereus, Klebsiellaaerogenes. Staphylococcus aureus and Escherichia coli were inhibited by two marine isolates M5 followed by M2.
A |
B |
C |
D |
E |
F |
Fig. 2: Antibacterial activity of the marine isolates by agar-well diffusion method
Characterization of M5 isolate
The M5 isolate exhibited maximum antibacterial potential against all the tested clinical isolates. The M5 isolate was further subjected to morphological and biochemical characterization and it was represented in table 4. Based on the morphological and biochemical characteristics the M5 isolate was identified as Pseudomonas sp.
Table 4: Morphological and biochemical characterization of M5 isolate
| Tests | Results | Tests | Results |
| Gram’s staining | Gram-negative | Triple sugar iron | K/K |
| Motility | Motile | Catalase | Positive |
| Indole | Negative | Urease | Negative |
| Methyl red | Negative | Carbohydrate fermentation | Acid formation |
| Voges-Proskauer | Positive | Oxidase | Positive |
| Citrate utilization | Positive | H2S production | Negative |
| Glucose | Negative | Sucrose | Negative |
16S rRNA analysis of M5 isolate
The isolate M5 which exhibited the maximum antibacterial activity was analyzed using 16S rRNA sequencing. The M5 isolate was confirmed as Pseudomonas japonica.
AGGTGCCCGTTGTGGCTAACACATGCAAGTCGAGCGGATGAGAAGAGCTTGCTCTTCGATTCAGCGGCGGACGGGTGAGTAATACCTAGGAATCTGCCTGGTAGTGGGGGACAACGTTTCGAAAGGAACGCTAATACCGCATACGTCCTACGGGAGAAAGCAGGGGACCTTCGGGCCTTGCGCTATCAGATGAGCCTAGGTCGGATTAGCTAGTTGGTGAGGTAATGGCTCACCAAGGCTACGATCCGTAACTGGTCTGAGAGGATGATCAGTCACACTGGAACTGAGACACGGTCCAGACTCCTACGGGAGGCAGCAGTGGGGAATATTGGACAATGGGCGAAAGCCTGATCCAGCCATGCCGCGTGTGTGAAGAAGGTCTTCGGATTGTAAAGCACTTTAAGTTGGGAGGAAGGGCAGTAAGCGAATACCTTGCTGTTTTGACGTTACCGACAGAATAAGCACCGGCTAACTCTGTGCCAGCAGCCGCGGTAATACAGAGGGTGCAAGCGTTAATCGGAATTACTGGGCGTAAAGCGCGCGTAGGTGGTTCGTTAAGTTGGATGTGAAATCCCCGGGCTCAACCTGGGAACTGCATCCAAAACTGGCGAGCTAGAGTAGGGCAGAGGGTGGTGGAATTTCCTGTGTAGCGGTGAAATGCGTAGATATAGGAAGGAACACCAGTGGCGAAAGCGACCACCTGGGCTCATACTGACACTGAGGTGCGAAAGCGTGGGGAGCAACAGGATTAGATACCCTGGTAGTCCACGCCGTAACGATGTCAACTAGCCGTTGGAATCCTTTGAGATTTTTAGTGGCGCAGCTAACGGCAATTTAAGTTGGAACGCCTGGGGAGTACTGACGCAAGGTAAGACTCAAATGAAGTTGGACTGGGCGAGAG

Fig. 3: Phylogenetic tree of Pseudomonas japonica
DISCUSSION
Marine ecosystem is a rich source of various natural eco-friendly products. Marine environment provides an excellent opportunity to provide compounds of rich diversity. The continuous selection of bacteria that are resistant against a wide range of antibiotics necessitates the discovery of novel unconventional sources of antibiotics, mainly in hospitals. Methicillin-resistant S. aureus (MRSA), Escherichiacoli O157:H7, Mycobacteriumtuberculosis and P. aeruginosa have been considered some of the most virulent microorganisms for the human population. Bacteria-bacterial pathogen interactions are having an increased interest in the area of biocontrol.
Marine soil sample was collected from Pichavaram, Chidambaram, Cuddalore district. The soil sample was serially diluted and plated on Zobell Marine Agar to get isolated colonies. Based on the distinct morphological characteristics, 10 isolates were selected for further studies.
The isolated 25 strains from sea water and a large number of bacteria could live on it. These bacteria species were generally not real symbiotic to the host but can instead be regarded as associated bacteria with the consanguineous relationship with their hosts [12].
The marine isolates were screened for antibacterial activity against seven clinical pathogens by Point inoculation method and the Agar-Well diffusion assay method.
Each of the 86 marine isolates was examined for their inhibition of growth of the remaining 85 isolates by agar-well diffusion assay and about 53.5% of these isolates exhibited antagonistic properties against other pelagic bacteria. In the present study, remarkably large fractions, six out of ten marine isolates are showing antibacterial activity. Among the bacteria isolated from Amazon basin 59 of 86 isolates (68.6%) displayed antimicrobial activity. Most of the strains inhibited Bacillus cereus and also showed activity against Corynebacteriumfimi, Escherichia coli, Staphylococcus aureus and Salmonella enteritidis [13].
Around six marine isolates of the present study exhibited antimicrobial activity against one or more clinical strains. The highest activity was found against Bacillus subtilis exhibited by the isolate M5. Maximum number of isolates inhibited clinical pathogens such as Klebsiella pneumonia and Bacillus cereus.
Many of the antibacterial interactions involved Pseudomonas sp. The genus Pseudomonasactively solubilizes phosphate in vitro and produces several antibiotics with high specificity against several microorganisms like Bacillussubtilis and Proteusvulgaris [14].
Current assays for antibacterial activity are inadequate because some antibiotic-producing bacteria may require the presence of an inducer compound produced in the presence of another bacterial species. These findings have important implications for the discovery of novel antimicrobial compounds from marine bacteria and may allow the development of new methods for screening novel compounds active against multi drug-resistant bacteria. Marine bacteria producing a pyrrole antibiotic had been isolated and identified by [15].
The isolate M5 presented the highest inhibition against all the 4clinical pathogens. M5 isolate was studied for the genus level identification by staining, motility and biochemical characteristics. After confirming the isolate M5 was Pseudomonas sp. it was further analyzed for species level identification using 16S rRNA sequencing and confirmed as Pseudomonas japonica.
CONCLUSION
It can be concluded that the isolation of Marine bacterial samples can offer a numbers of microbial strains for sources of new biomolecules from Marine sources. This study indicated that certain strains of bacteria could be induced to produce antibiotic.
FUNDING
Nil
AUTHORS CONTRIBUTIONS
All the authors have contributed equally.
CONFLICT OF INTERESTS
Declared none
REFERENCES
Wilson CA, Harold Stevenson LH. The dynamics of the bacterial population associated with a salt marsh. J Exp Mar Biol Ecol. 1980;48(2):123-38. doi: 10.1016/0022-0981(80)90012-X.
Nair S, Simidu U. Distribution and significance of heterotrophic marine bacteria with antibacterial activity. Appl Environ Microbiol. 1987;53(12):2957-62. doi: 10.1128/aem.53.12.2957-2962.1987, PMID 3435149.
Austin B. Quantification of marine microbial populations. In: Austin B. editor. Marine microbiology. Cambridge University Press; 1992. p. 31-42.
Rosenfeld WD, Zobell CE. Antibiotic production by marine microorganisms. J Bacteriol. 1947;54(3):393-8. doi: 10.1128/jb.54.3.393-398.1947, PMID 16561373.
Grein A, Meyers SP. Growth characteristics and antibiotic production of actinomycetes isolated from littoral sediments and materials suspended in seawater. J Bacteriol. 1958;76(5):457-63. doi: 10.1128/jb.76.5.457-463.1958, PMID 13598702.
Wratten SJ, Wolfe MS, Andersen RJ, FaulkneR DJ. Antibiotic metabolites from a marine pseudomonad. Antimicrob Agents Chemother. 1977;11(3):411-4. doi: 10.1128/AAC.11.3.411, PMID 324390.
Tagg JR, Dajani AS, Wannamaker LW. Bacteriocins of gram-positive bacteria. Bacteriol Rev. 1976;40(3):722-56. doi: 10.1128/br.40.3.722-756.1976, PMID 791239.
Klaenhammer TR. Bacteriocins of lactic acid bacteria. Biochimie. 1988;70(3):337-49. doi: 10.1016/0300-9084(88)90206-4, PMID 3139051.
Chitnis V, Patil S, Kant R. Hospital effluent: a source of multiple drug-resistant bacteria. Curr Sci. 2000;79:83-4.
Breiman RF, Butler JC, Tenover FC, Elliott JA, Facklam RR. Emergence of drug-resistant pneumococcal infections in the United States. JAMA. 1994;271(23):1831-5, PMID 8196139.
Lechevalier HA, Corke CT. The replica plate method for screening antibiotic-producing organisms. Appl Microbiol. 1953;1(2):110-2. doi: 10.1128/am.1.2.110-112.1953, PMID 13031518.
Shewan JM, Hobbs G, Hodgkiss W. A determinative scheme for the identification of certain genera of gram-negative bacteria, with special reference to the pseudomonadaceae. J Appl Bacteriol. 1960;23(3):379-90. doi: 10.1111/j.1365-2672.1960.tb00211.x.
Amanda S, Motta F Cladera-Olivera, Brandelli A. Screening for antimicrobial activity among bacteria isolated from the Amazon basin. Braz J Microbiol. 2004;35:307-10.
Girmay Kalayu. Phosphate solubilizing microorganisms: promising approach as biofertilizers. Int J Agro. 2019. https://doi.org/10.1155/2019/4917256
Burkholder PR, Pfister RM, Leitz FH. Production of a pyrrole antibiotic by a marine bacterium. Appl Microbiol. 1966;14(4):649-53. doi: 10.1128/am.14.4.649-653.1966, PMID 4380876.